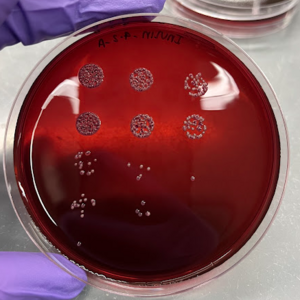

Source: Universidad de la Sabana
Mariana Guzmán, a graduate in Agro-industrial Production Engineering from the School of Engineering, completed her professional internship at Purdue University in the United States. Her interest in studying the link between diet, intestinal microbiota and health has led her on a research path that will help develop new treatments for the reduction of chronic diseases such as obesity and diabetes.
Between microscopes, test tubes, experiments, data analysis, Mariana spends most of her day. In her international internship she assisted in the generation of data for the development of a mathematical model that will help simulate and predict the microbial interactions that occur within the microorganisms that live in our digestive tract, which feed on the different types of fiber that we consume daily. This project is developed in conjunction with professionals, such as Dr. Steve Lindemann at the Diet-Microbiome Interactions Lab.
“My professional training has been strongly marked the last few months by my mentors, mainly Dr. Lindemann and the PhD students, who have not only guided me in my research, but have been concerned about teaching me to grow and open my own path, in order to move towards what I am really passionate about: going deeper into the area of nutrition.”
She has faced these challenges with determination and today they have made her the protagonist of major developments in public health. Mariana recalls that the most difficult thing was to understand how research worked in that particular environment, as she had basic knowledge of microbiology and mathematical modeling, but did not know the dynamics:
“Every lab has its personality and culture, which led me to understand and adapt to this environment. Once I found my place and my rhythm, the research started to be much more effective,” she said.
By better understanding how diet and gut microbiota influence health, it is possible to develop strategies that help reduce obesity and diabetes in the population. Hence, the contribution of research in the field of bioproduction engineering.
Her interest in studying Agro-industrial Production Engineering (now Bioproduction Engineering) at the Universidad de La Sabana was born from a dream of uniting her main passions: food, nutrition and the science behind them. “What I was looking for was a career that would give me enough tools to have a wide field of action at the end of my studies.”

Petri dish cultivation by the drip sealing method using a massive plate. To determine the amount of bacteria: E. coli and K. Pneumoniae. Source: Universidad de la Sabana
Women Engineers with Sustainable Solutions
Mariana shares her passion for research with other women who believe in the power of science, technology, engineering and mathematics as the way to drive the development of a better society.
“I am proud to be a research engineer who works to contribute from my field of action, surrounded by women researchers who are my great source of inspiration. It is gratifying to see how the perspectives and solutions that we as women bring to the world of engineering and academia are appreciated,” she says.
For Mariana, “the knowledge gained from research can also help in the development of new treatments and therapies based on the manipulation of the intestinal microbiota, as well as boost innovation in the food industry, with the development of new products,” she says.
From her role as a bioproduction engineer, she has learned a lot. One of them is to understand that research is a job with many approaches, a task that requires permanent updating, good colleagues who trust in the work of others, to take on great challenges and to remember some anecdotes that inspire to be better every day.
“The world is counting on our skills and ideas”
Today, the world requires comprehensive solutions to problems. Therefore, an engineer who has the ability to analyze these situations from an analytical and quantitative perspective, focused on biological systems and on understanding their particularities, challenges and opportunities, is fundamental for our development.
Regarding the future of engineering, Mariana assures that: “today's world needs engineers who are aware of their environment, who understand that the numbers and code we see on screens affect real people, with names and surnames. We must be engineers committed to the people who count on us, the world counts on us, on our skills and ideas”.
Finally, Mariana is ready to continue contributing to food science research. In August 2024, she started her master's studies in Food Science at Purdue University, and will continue her work in Dr. Lindemann's lab, where she has already made her mark.
Learn more about the research
Mariana's research focuses on inulin, a type of dietary fiber found in foods such as onions. Humans do not have the capacity to digest it in the stomach, so it reaches the intestine “intact”. In the large intestine, also called colon, we have important microorganisms for our health, because they take this type of fiber that has not been digested as food, and as they grow, they produce necessary and beneficial substances for us.
That food is known as “prebiotic”, and some microorganisms “probiotic. The community of microorganisms that live in our digestive tract is generally referred to as the gut microbiome or microbiota. They go through the process of fermentation, thus consuming dietary fiber.
Read here the original article in Spanish!